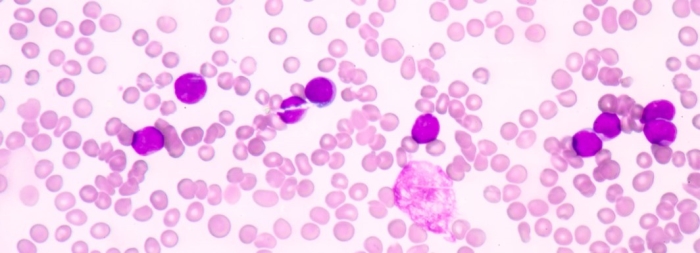

Leukaemia
Leukaemia
Leukaemia begins in a white blood cell in the bone marrow. The genetic material is damaged (becomes mutated) turning it into a leukemic cell. The leukemic cell is an immature type of white blood cell called a blast that cannot function normally, but it grows and survives better than normal cells and over time the blasts begin to take over the bone marrow. The production of adequate numbers of healthy blood cells, such as platelets, red blood cells and healthy white blood cells is reduced. The blast cell is unable to carry out the normal functions of a white blood cell and therefore the patient’s ability to fight infection is lowered. The type of leukaemia depends on which kind of white blood cell is affected. There are many different types of white blood cells. These include myeloid and lymphoid cells. Myeloid cells normally help to fight bacterial infections, defending the body against parasites and preventing the spread of tissue damage. Myeloid cells develop into red blood cells, white blood cells and platelets while Lymphoid stem cells develop into white blood cells called T and B lymphocytes. Leukaemia can also be divided into two main groups depending on how fast the disease develops. Acute leukaemia develops quickly, whereas chronic leukaemia develops more slowly. As a result, there are four main types of leukaemia based on the rate at which the leukaemia progresses and what type of abnormal blood cell replaces the normal blood and marrow cells.
- Acute myeloid leukaemia (AML) is a relatively rare type of cancer with most cases occurring in people who are age 60 or over. About 80 people a year are diagnosed with AML in Ireland and it is more common in boys and men than it is in girls and women. It is a cancer of myeloid cells that are called blast cells. The blast cells are rapidly overproduced crowding out the normal cells and preventing the production of healthy blood cells needed by your body.
- Acute lymphoblastic leukaemia (ALL) is a relatively uncommon cancer but is the most common cancer to affect children. About 85% of cases of ALL occur in children who are under the age of 15. ALL is a cancer of immature lymphoid cells (blast cells). The blast cells divide and grow rapidly in an uncontrolled way.
- Chronic myeloid leukaemia (CML) is quite a rare condition and there are on average 33 people diagnosed in Ireland with Chronic Myeloid Leukemia (CML) every year. It is more common in people aged between 40-60. It is a slow-growing cancer of the immature myeloid cells (blast cells). It progresses slowly over the course of many years and no treatment is required at this stage. However over time the blast cells overcrowd the bone marrow (blast crisis) and treatment becomes necessary.
- Chronic lymphoblastic leukaemia is the most common leukaemia in the western world with most cases developing in people over the age of 55. There are about 100 cases a year in Ireland. It is a slow-growing cancer of immature lymphocytes (blast cells).

